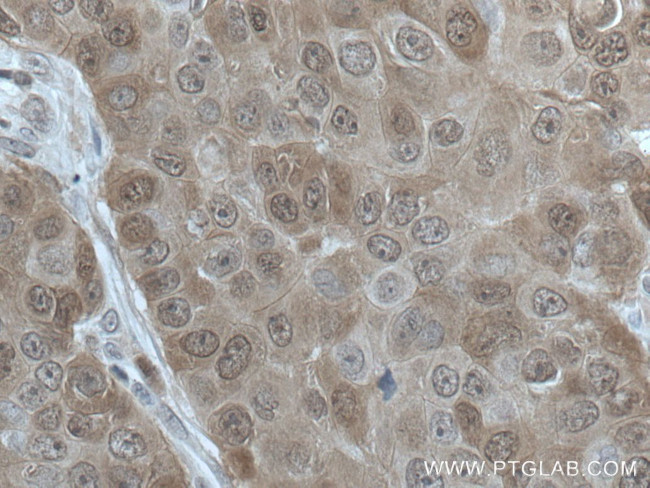
HN1 Antibody in Immunohistochemistry (Paraffin) (IHC (P))
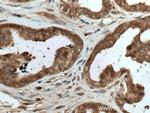
HN1 Antibody in Immunohistochemistry (Paraffin) (IHC (P))

Search
Proteintech
HN1 Polyclonal Antibody
{{$productOrderCtrl.translations['antibody.pdp.commerceCard.promotion.promotions']}}
{{$productOrderCtrl.translations['antibody.pdp.commerceCard.promotion.viewpromo']}}
{{$productOrderCtrl.translations['antibody.pdp.commerceCard.promotion.promocode']}}: {{promo.promoCode}} {{promo.promoTitle}} {{promo.promoDescription}}. {{$productOrderCtrl.translations['antibody.pdp.commerceCard.promotion.learnmore']}}
产品信息
14914-1-AP
种属反应
宿主/亚型
分类
类型
抗原
偶联物
形式
浓度
规格
纯化类型
保存液
内含物
保存条件
运输条件
产品详细信息
Immunogen sequence: MTTTTTFKG VDPNSRNSSR VLRPPGGGSN FSLGFDEPTE QPVRKNKMAS NIFGTPEENQ ASWAKSAGAK SSGGREDLES SGLQRRNSSE ASSGDFLDLK GEGDIHENVD TDLPGSLGQS EEKPVPAAPV PSPVAPAPVP SRRNPPGGKS SLVLG (1-154 aa encoded by BC001420)
靶标信息
HN1 (hematopoietic- and neurologic-expressed sequence 1) is a highly conserved protein that is expressed in developing and regenerating tissues. Overexpression of HN1 has been reported in various tumors like glioma and breast cancer. Hn1 has also been reported as a marker for human ovarian carcinoma and can distinguish epithelial ovarian carcinoma cells from normal ovarian surface epithelial cells. This collective information suggests that HN1 is involved in processes associated with cell proliferation, repair and/or growth.
仅用于科研。不用于诊断过程。未经明确授权不得转售。
生物信息学
蛋白别名: Androgen-regulated protein 2; Hematological and neurological expressed 1 protein; hematological and neurological expressed sequence 1; HN1B; HN1C; Jupiter microtubule associated homolog 1; unnamed protein product
基因别名: ARM2; HN1; HN1A; JPT1
UniProt ID: (Mouse) P97825, (Rat) Q6AXU6, (Human) Q9UK76
Entrez Gene ID: (Mouse) 15374, (Rat) 287828, (Human) 51155